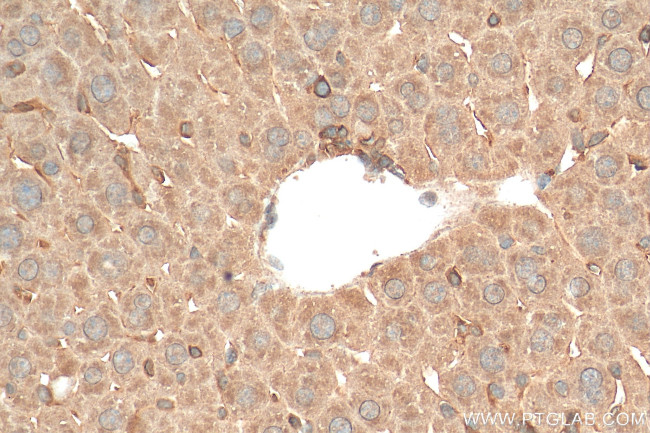
MYD88 Antibody in Immunohistochemistry (Paraffin) (IHC (P))

Search
Proteintech
MYD88 Polyclonal Antibody
{{$productOrderCtrl.translations['antibody.pdp.commerceCard.promotion.promotions']}}
{{$productOrderCtrl.translations['antibody.pdp.commerceCard.promotion.viewpromo']}}
{{$productOrderCtrl.translations['antibody.pdp.commerceCard.promotion.promocode']}}: {{promo.promoCode}} {{promo.promoTitle}} {{promo.promoDescription}}. {{$productOrderCtrl.translations['antibody.pdp.commerceCard.promotion.learnmore']}}
产品信息
29946-1-AP
种属反应
已发表种属
宿主/亚型
分类
类型
抗原
偶联物
形式
浓度
规格
纯化类型
保存液
内含物
保存条件
运输条件
产品详细信息
Immunogen sequence: LAEEMGFEYL EIRELETRPD PTRSLLDAWQ GRSGASVGRL LELLALLDRE DILKELKSRI EEDCQKYLGK QQNQESEKPL QVARVESSVP QTKELGGITT L
靶标信息
Myeloid differentiation Marker 88 (MyD88) is an adaptor molecule for the Toll/IL-1R and is involved in the inflammatory response induced by IL-1, IL-18 and LPS. MyD88 recruits IRAK to IL-1 receptor complex in response to IL-1. This pathway further leads to activation of NF-kB. MyD88 has a wide tissue distribution.
仅用于科研。不用于诊断过程。未经明确授权不得转售。
生物信息学
蛋白别名: myeloid differentiation primary response gene 88; Myeloid differentiation primary response protein MyD88
基因别名: Myd88
UniProt ID: (Rat) Q6Y1S1, (Mouse) P22366
Entrez Gene ID: (Rat) 301059, (Mouse) 17874